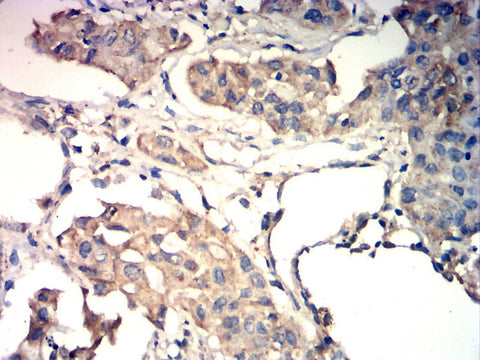

You have no items in your shopping cart.
Product Profile
Product Name | Anti-HEXB antibody |
---|---|
Antibody Type | Primary Antibodies |
Immunogen | Polypeptide |
Key Feature
Clonality | Polyclonal |
---|---|
Isotype | IgG |
Host Species | Rabbit |
Tested Applications | ELISAICC/IFIHCWB |
WB:1:200-1:2000 IHC:1:200-1:1000 ICC/IF:1:100-1:500 |
|
Species Reactivity | HumanMouseRat |
Concentration | 1 mg/ml |
Purification | Protein A |
Target Information
Gene Symbol | HEXB |
---|---|
Gene Synonyms |
ENC-1AS
HEL-248 HEL-S-111 |
Gene Full Name | hexosaminidase subunit beta |
Gene Summary |
Hexosaminidase B is the beta subunit of the lysosomal enzyme beta-hexosaminidase that, together with the cofactor GM2 activator protein, catalyzes the degradation of the ganglioside GM2, and other molecules containing terminal N-acetyl hexosamines. Beta-hexosaminidase is composed of two subunits, alpha and beta, which are encoded by separate genes. Both beta-hexosaminidase alpha and beta subunits are members of family 20 of glycosyl hydrolases. Mutations in the alpha or beta subunit genes lead to an accumulation of GM2 ganglioside in neurons and neurodegenerative disorders termed the GM2 gangliosidoses. Beta subunit gene mutations lead to Sandhoff disease (GM2-gangliosidosis type II). Alternatively spliced transcript variants encoding different isoforms have been found for this gene. [provided by RefSeq, May 2014]
Hide
|
Molecular Weight(MW) | 63 KDa |
Source | Rabbit |
Cellular Localization | Lysosome |
Purification | Protein A |
Application

WB
Western blot analysis using HEXB antibody against THp-1 (1),A431(2) cell lysate.
IHC
Immunohistochemical analysis of paraffin-em

ICC/IF
Immunofluorescence analysis of Hela cells using HEXB antibody (green). Blue: DAPI fluorescent DNA dye. Red: Actin filaments have been labeled with Alexa Fluor- 555 phalloidin.
Application Notes |
WB:1:200-1:2000
IHC:1:200-1:1000 ICC/IF:1:100-1:500 |
---|
Additional Information
Form | Liquid |
---|---|
Storage Instructions | Shipped at 4°C. Store at +4°C short term (1-2 weeks). Store at -20°C long term. Avoid freeze / thaw cycle. |
Storage Buffer | Purified antibody in PBS with 0.05% sodium azide. |
When can I expect my order to ship?
Most orders are filled and shipped within 2-3 business days from the time they are received.
Our standard shipping usually take 2-5 days.
We also provide express shippping for time-sensitive deliveries.
Email contact@biofargo.com if you have any requirements.
No data